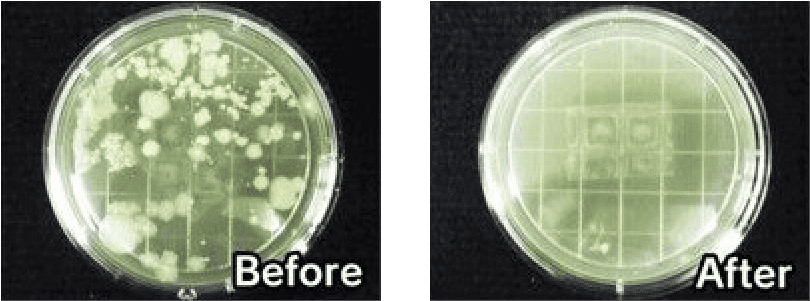
抗菌力

車内空間(除菌・消臭)
自動車の車内をキレイに保つ、
次世代ナノテクノ抗菌・消臭剤
「光ギンテック」
染みついた臭いもスッキリ消臭!
車内の隅々まで丸ごと抗菌処理!
ウイルス対策に!
「光ギンテック」は、さまざまな
分野・身近な場所で使用されています
-

新幹線
-

鉄道
-

医療施設
-

ホテル
-

食品工場
「光ギンテック」のここがすごい!
消臭力

タバコのニオイ 汗のニオイ
※アスカテック( 株) 調べ
抗菌力
抗菌効果は約6ヶ月持続!
※アスカテック( 株) 調べ施工料金(税込)

車室内用
2,860円

エアコン用
4,686円
施工するなら
セットが
お得!
-

車室内用
- +
-

エアコン用
セット料金
6,010円


入庫予約はこちら
お近くの店舗を探す

